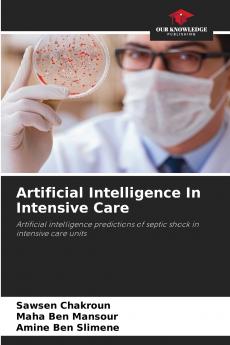
Artificial Intelligence In Intensive Care

English
Paperback
₹5293
₹6820
22.39% OFF
(All inclusive*)
Delivery Options
Please enter pincode to check delivery time.
*COD & Shipping Charges may apply on certain items.
Review final details at checkout.
Looking to place a bulk order? SUBMIT DETAILS
About The Book
Description
Author(s)
Early detection of septic shock is crucial for improving patient outcomes. This study aims to develop a machine learning model using XGBoost to predict septic shock six hours in advance. The model was trained on a public dataset comprising 40336patients. It was tested on a portion of this set achieving an accuracy of 0.97 and an AUC of 0.874. Predictions were also made for 8 10 and 12 hours ahead giving accuracies of 0.899 0.891 and 0.8954 and AUCs of 0.867 0.8639 and 0.8530 respectively.In addition the model was tested on a local dataset from Fattouma Bourguiba University Hospital comprising 30 patients. For prediction at 6 hours on the local dataset the model achieved an accuracy of 0.89 and an AUC of 0.74. Predictions for 8 10 and 12 hours ahead showed accuracies of 0.8861 0.8772 and 0.8718 and AUCs of 0.73 0.72 and 0.72 respectively. The XGBoost model shows potential for early detection of septic shock but requires further testing and optimization for clinical application.
Delivery Options
Please enter pincode to check delivery time.
*COD & Shipping Charges may apply on certain items.
Review final details at checkout.
Details
ISBN 13
9786208695538
Publication Date
-27-02-2025
Pages
-52
Weight
-85 grams
Dimensions
-152x229x3.16 mm